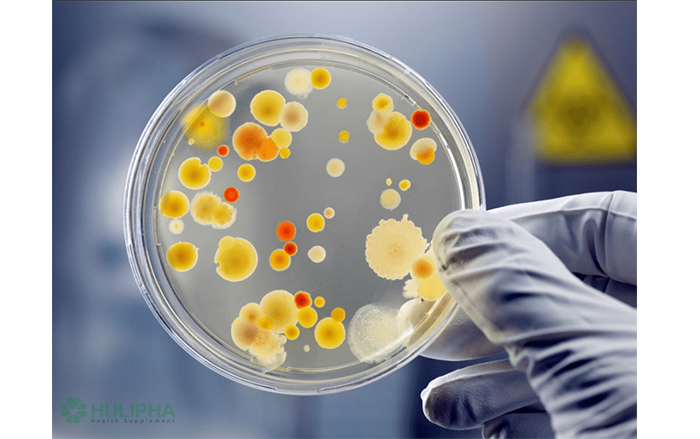
Tìm Hiểu Về Các Loại Vi Sinh Vật Trên Trái Đất

Góc Sức Khỏe Nhân Sinh

Chúng ta đều biết giấc ngủ là điều quan trọng để duy trì sức khỏe tốt, nhưng vẫn còn rất nhiều câu hỏi chưa được giải đáp. Và, trong nhiều thiên niên kỷ, xuất hiện nhiều loại huyền thoại và sự thật nửa vời.
xem chi Tiết
Sự phức tạp của cuộc sống, từ những vi sinh vật nhỏ nhất đến những cây cối và động vật lớn nhất, thật đáng kinh ngạc. Họ sinh vật phổ biến nhất là vi sinh vật.
xem chi Tiết
Một số người nghĩ rằng ngủ ngửa giống như ma cà rồng, thây ma và Frankenstein, nhưng hóa ra ngủ ngửa có thể là một giải pháp đơn giản, hiệu quả cho rất nhiều vấn đề sức khỏe.
xem chi Tiết
Hầu hết chúng ta đều nhớ về một thời mà chúng ta có thể ăn bất cứ thứ gì chúng ta muốn và không bị tăng cân. Nhưng một nghiên cứu mới cho thấy sự trao đổi chất, tốc độ đốt cháy calo, thực sự đạt đỉnh sớm hơn nhiều và bắt đầu suy giảm không thể tránh khỏi muộn hơn bạn nghĩ.
xem chi Tiết
Da trên cơ thể có rất nhiều vai trò. Ví dụ như giúp ngăn chặn mầm bệnh và bảo vệ phần bên trong cơ thể chúng ta. Da cũng giúp chúng ta giữ ấm khi trời lạnh và hạ nhiệt khi trời nóng.
xem chi Tiết
Một nghiên cứu mới từ Đại học Nam Úc cho thấy một số loại béo phì dẫn đến giảm chất xám của não và nghiên cứu mối liên quan của nó với nguy cơ sa sút trí tuệ và đột quỵ.
xem chi Tiết
Viêm gan thường phát triển do nhiễm vi-rút hoặc uống rượu, nhưng nó cũng có thể là do độc tố, thuốc và một số tình trạng nhất định, bao gồm cả tình trạng tự miễn dịch.
xem chi Tiết
Vắc xin Pfizer/BioNTech BNT162b2, có hiệu quả cao và an toàn trong việc bảo vệ chống lại nhiễm trùng Covid-19, bao gồm cả biến thể beta tương đối kháng B.1.351.
xem chi Tiếtnâng cao sức khoẻ con người được tốt hơn cả hiện tại và tương lai


Huyền Thoại Y Học: Những Lầm Tưởng Về Bệnh Ung Thư

Huyền Thoại Y Học: Lầm Tưởng Về Bệnh Viêm Khớp

Huyền Thoại Y Học: Những Lầm Tưởng Về Dị Ứng

Huyền Thoại Y Học: Những Lầm Tưởng Về Hiến Máu

Biến Thể Delta Của SARS-CoV-2 Nguy Hiểm Như Thế Nào?

Lợi Ích Và Tác Dụng Phụ Của Axit Béo Omega-3





















